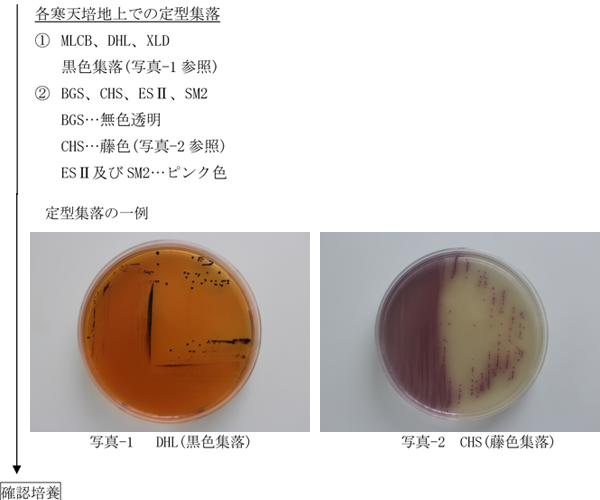

|
食品、添加物等の規格基準に定めるサルモネラ属菌の試験法について
一般財団法人 食品分析開発センターSUNATEC
微生物検査室 1 はじめに昭和34年厚生省告示第370号「食品、添加物等の規格基準」の食肉製品のうち、非加熱食肉製品、特定加熱食肉製品及び加熱食肉製品(但し、加熱殺菌した後容器包装に入れたもの)、並びに食鳥卵(但し、鶏の液卵を殺菌したもの)の成分規格としてサルモネラ属菌の規格が設定されている。これまでサルモネラ属菌の試験法は、食肉製品については平成5年3月17日付け厚生省生活衛生局長通知「衛乳第54号」、食鳥卵(殺菌液卵)については平成10年11月25日付け厚生省生活衛生局長通知「生衛発第1674号」でそれぞれ定められていたが、平成27年7月29日付け厚生労働省通知「食安発0729号第4号」で黄色ブドウ球菌の試験法と合わせて改正された。 2 試験法について試験法を図-1に示す。
3 まとめ今回、改正されたサルモネラ属菌の試験法を紹介した。本試験法は、国際整合性がありISO 6579:2002と妥当性確認がなされた試験法である。通知法改正前は、食肉製品と食鳥卵(殺菌液卵)のそれぞれを対象にした異なる試験法によりサルモネラ属菌の検査を実施する必要があったが、通知法改正後は本試験法に統一されたことになる。 4 参考資料1)平成5年3月17日付け厚生省生活衛生局長通知「衛乳第54号」 2)平成10年11月25日付け厚生省生活衛生局長通知「生衛発第1674号」 3)平成27年7月29日付け厚生労働省通知「食安発0729第4号」 4)平成28年1月28日付け医薬・生活衛生局生活衛生・食品安全部基準審査課事務連絡 5)国立医薬品食品衛生研究所ホームページ サナテックメールマガジンへのご意見・ご感想を〈e-magazine@mac.or.jp〉までお寄せください。 |
| Copyright (C) Food Analysis Technology Center SUNATEC. All Rights Reserved. |